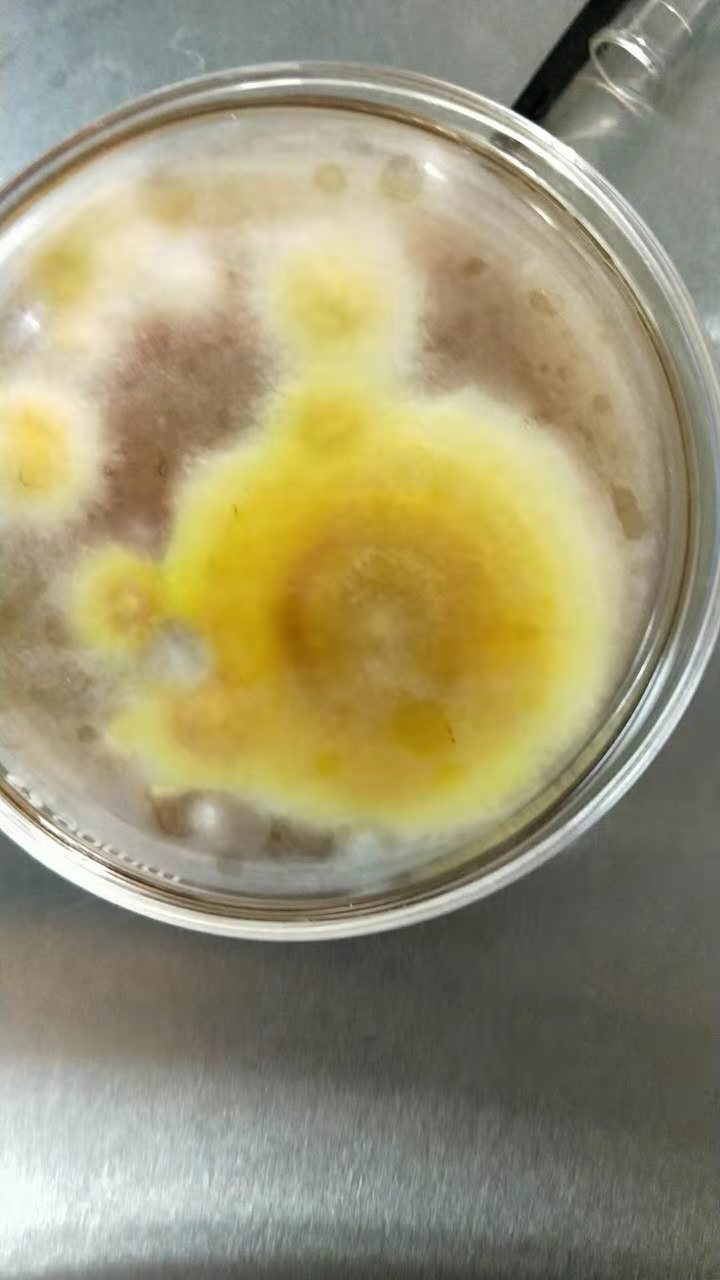

生命科学学院孙金旭教授硕士研究生期间的课题组研究内容“裂褶菌耐缺氧发酵物及其发酵方法与培养基”经过多年的研究与应用喜获北京市发明专利二等奖。多年来,孙金旭教授一直从事真菌发酵方面的研究,先后立项省市级课题5项,发表核心期刊论文6篇,指导学生获河北省挑战杯大学生课外科技作品二等奖,三等奖。自2015年以来,孙教授带领的真菌发酵研发团队分别对桑黄、冬虫夏草、灵芝、牛樟芝、香菇菌、灰树花、绣球等进行了菌种分离纯化、培养基优化、发酵工艺参数优化、相关产品开发等进行了研究,为这些稀有真菌的发酵生产打下良好的基础,研究成果香菇菌发酵培养基及培养方法,培养基原料成本降低50%,发酵周期缩短2天,菌体及多糖产量提高15%以上,该技术正在企业进行5吨发酵罐发酵中试阶段。
秉承我校培养高素质应用型人才、服务地方经济的办学理念,孙金旭教授真菌发酵研究团队努力奋进、砥砺前行,为我校建设应用技术大学努力拼搏。